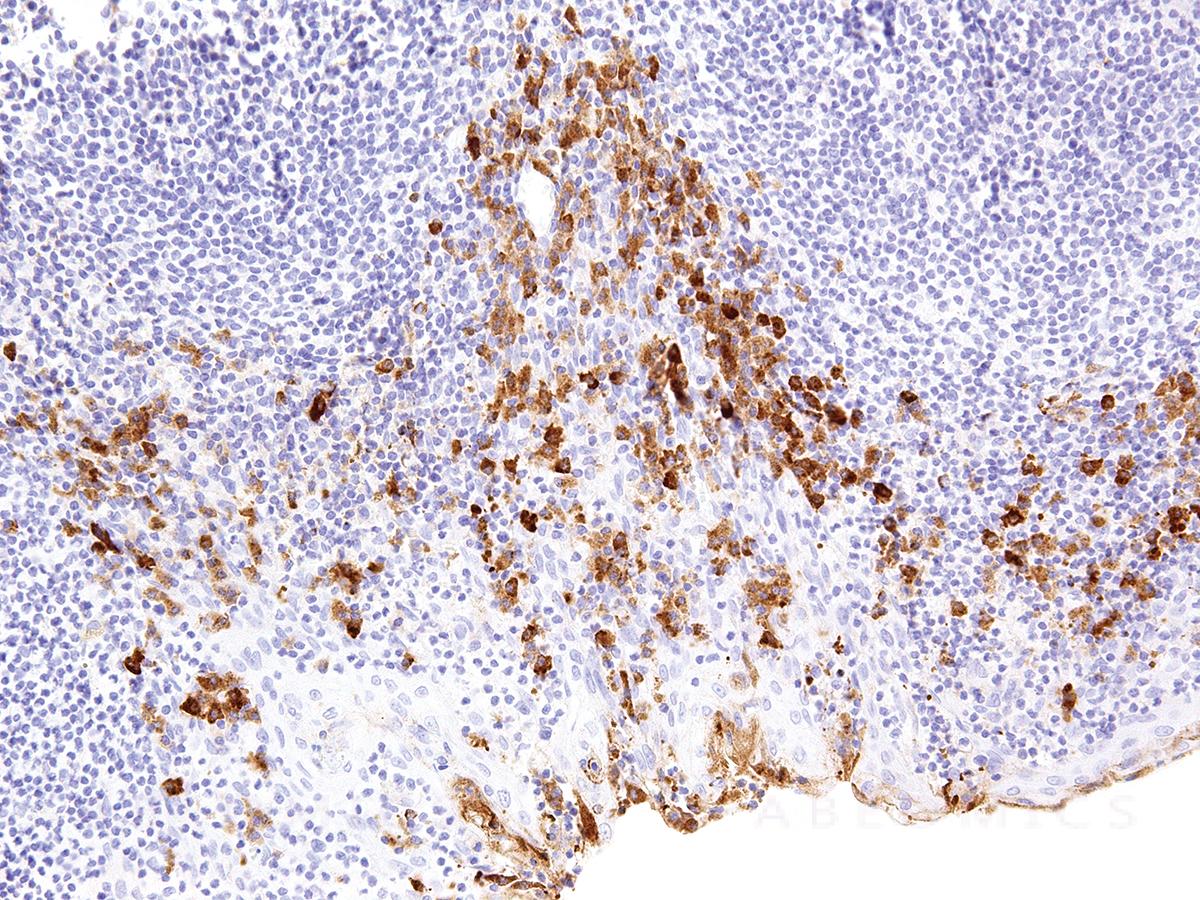

Anti-CTLA-4 Monoclonal Antibody (Clone:IHC004)(Discontinued)
Figure 1: Immunohistochemical analysis of CTLA-4 (Clone: IHC004) on Tonsil
Roll over image to zoom in

Shipping Info:
For estimated delivery dates, please contact us at [email protected]
Format : | Purified |
Amount : | 7 ml |
Purification : | Protein A/G Chromatography |
Content : | Tris Buffer, pH 7.3 - 7.7, with 1% BSA and <0.1% Sodium Azide |
Storage condition : | Store at 2°C - 8°C. Do not freeze. |
Cytotoxic T-lymphocyte-associated protein 4 (CTLA-4) is a receptor on T Helper cells that functions as an immune checkpoint and downregulator of immune responses. Mutations in CTLA-4 are associated with insulin-dependent diabetes mellitus, Hashimoto’s thyroiditis, Graves’ disease, systemic lupus erythematosus (SLE), celiac disease, primary biliary cirrhosis, thyroid-associated orbitopathy, multiple sclerosis, and other autoimmune diseases. The spliced variant of CTLA-4 in SLE is present in the patient’s serum. Haploinsufficiency of CTLA-4 causes the immune system disorder known as CTLA-4 deficiency or CHAI disease (CTLA4 haploinsufficiency with autoimmune infiltration).
Recommended dilutions: Immunohistochemical analysis: 1:100 - 1:200. However, this need to be optimized based on the research applications.
For Research Use Only. Not for use in diagnostic/therapeutics procedures.
Subcellular location: | Cell membrane |
Post transnational modification: | Phosphorylation at Tyr-201 prevents binding to the AP-2 adapter complex, blocks endocytosis, and leads to retention of CTLA4 on the cell surface. |
Tissue Specificity: | Widely expressed with highest levels in lymphoid tissues. Detected in activated T-cells where expression levels are 30- to 50-fold less than CD28, the stimulatory coreceptor, on the cell surface following activation. |
BioGrid: | 107875. 109 interactions. |
There are currently no product reviews
|